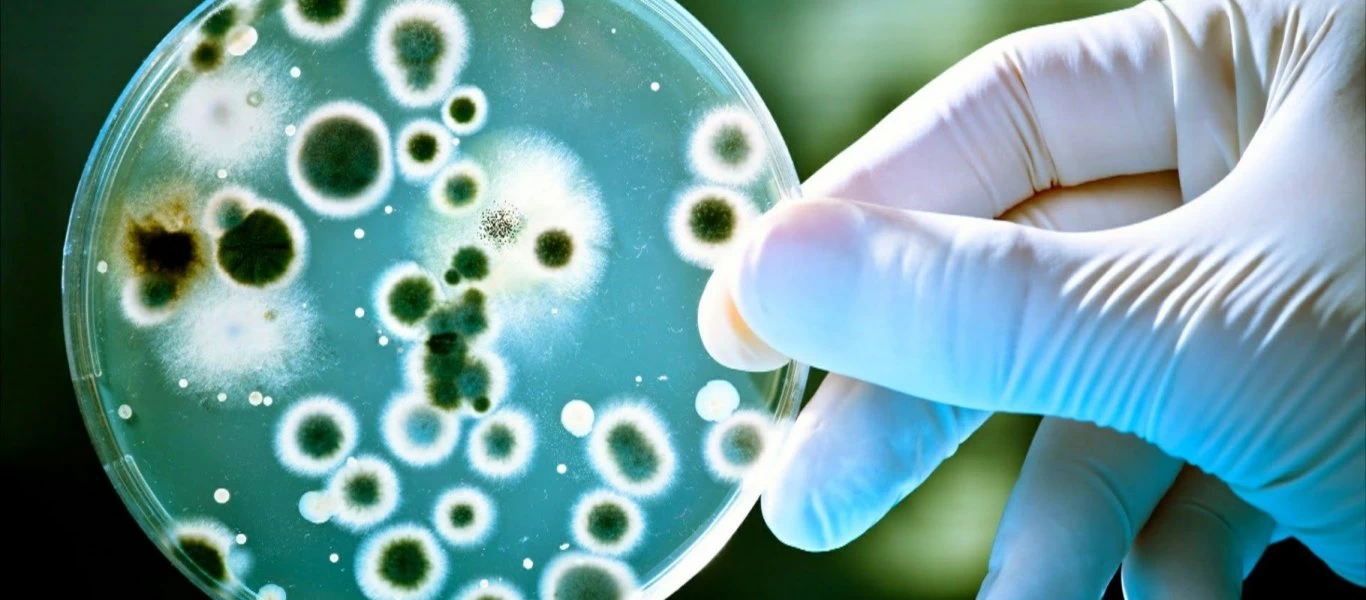
Τρόμος στην Αυστραλία: Σε έξαρση βακτήριο που «τρώει» σάρκες

ΥΓΕΙΑ
-

Σαν Μαρίνο: «Αξιολογούμε το Sputnik V απολύτως θετικά - Είναι αξιόπιστο εμβόλιο»
Ο υπουργός Υγείας του Σαν Μαρίνο, Roberto Ciavatta, κατά τη διάρκεια συνέντευξής του, τόνισε πως η χρήση του ρωσικού Spuntik V κατά του κορωνοϊού στη χώρα έχει δείξει πως είναι ένα αξιόπιστο εμβόλιο.H...
Read More » -

Μπάχαλο: Μέλος της επιτροπής που αποφασίζει είπε πως δεν έχει καταλάβει τι ισχύει με τις διαδημοτικές μετακινήσεις!
Ένα πραγματικό μπάχαλο, καθώς ο Αλκιβιάδης Βατόπουλος, μέλος της επιτροπής των «ειδικών» που αποφασίζει, με συχνή παρουσία στα ΜΜΕ, υποστήριξε σε τηλεοπτική του συνέντευξη πως... δεν έχει καταλάβει ού...
Read More » -

Υποθυρεοειδισμός: Δείτε ποιες είναι οι τροφές που πρέπει να τρώτε & ποιες όχι
Ως υποθυρεοειδισμός, ορίζεται η κατάσταση κατά την οποία μειώνεται η λειτουργία του θυρεοειδούς αδένα με αποτέλεσμα την παραγωγή χαμηλών επιπέδων θυρεοειδικών ορμονών στο σώμα.Ο υποθυρεοειδισμός είναι...
Read More » -

Eπανάκτηση στα πρωτότυπα φάρμακα όσο αυξάνονται οι πωλήσεις
Χωρίς να λαμβάνεται υπόψιν το ποσοστό ανάπτυξης που καταγράφηκε σε σχέση με την προηγούμενη χρονιά, θα υπολογίζεται στο εξής η υποχρεωτική επιστροφή clawback για τα πρωτότυπα φάρμακα που έχασαν την πρ...
Read More » -
Τρόμος στην Αυστραλία: Σε έξαρση βακτήριο που «τρώει» σάρκες
Συναγερμός έχει σημάνει στην νοτιοανατολική Αυστραλία, καθώς μια περίεργη νόσος τρομοκρατεί τους κατοίκους της περιοχής.Ειδικότερα, τα πρώτα σημάδια της μοιάζουν με ηλιακά εγκαύματα στο δέρμα, τα οποί...
Read More » -

Το Βιετνάμ παρέλαβε τις πρώτες δόσεις του εμβολίου της AstraZeneca
Το Βιετνάμ παρέλαβε σήμερα 811.000 δόσεις του εμβολίου κατά του κορωνοϊού της AstraZeneca.Η χώρα αυτή της Νοτιοανατολικής Ασίας, η οποία ξεκίνησε το πρόγραμμα εμβολιασμού τον περασμένο μήνα, στοχεύει ...
Read More » -

A.Eξαδάκτυλος: «Αν τα πράγματα δεν πάνε καλά με το λιανεμπόριο δεν θα ανοίξει τίποτα άλλο»
Την άποψη ότι δεν αρκούν τα self test και ότι χρειάζεται να ομαλοποιηθεί και η πορεία της πανδημίας για να γίνει το επόμενο βήμα (στο άνοιγμα της χώρας) εξέφρασε ο Θανάσης Εξαδάκτυλος, πρόεδρος του Πα...
Read More » -

Υπόταση: Με τη σωστή ενυδάτωση δεν θα σας πέφτει η πίεση
Στο ερώτημα που αφορά στους λόγους που μπορεί η αρτηριακή πίεση να μειωθεί αρκετά και κάποιες φορές να τόσο πολύ που να προκαλεί ζαλάδες και αδυναμία προσπαθεί να απαντήσει ο ειδικός του Χάρβαρντ, Δρ....
Read More » -

Εμβόλιο Johnson & Johnson - ΗΠΑ: Περίπου 15 εκατ. δόσεις καταστράφηκαν από ανθρώπινο λάθος σε εργοστάσιο
Σύμφωνα με την εφημερίδα «The New York Times», περίπου 15 εκατομμύρια δόσεις του μονοδοσικού εμβολίου κατά του κορωνοϊού της Johnson & Johnson καταστράφηκαν λόγω ανθρώπινου σφάλματος σε εργοστάσιο...
Read More » -

Κορονοϊός: Αυξημένη η πιθανότητα πολυοργανικής δυσλειτουργίας στους ασθενείς μετά το εξιτήριο
Οι άνθρωποι που παίρνουν εξιτήριο από το νοσοκομείο μετά από νοσηλεία λόγω Covid-19 εμφανίζουν αυξημένα ποσοστά βλαβών σε διάφορα όργανα του σώματός τους («πολυοργανική δυσλειτουργία») σε σχέση με τον...
Read More »
